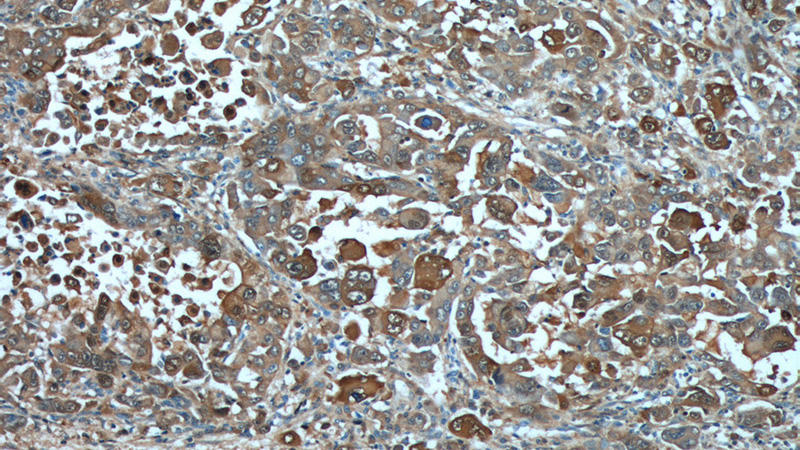
Immunohistochemistry of paraffin-embedded human liver cancer tissue slide using Catalog No:114963(S100A6 Antibody) at dilution of 1:200 (under 10x lens).
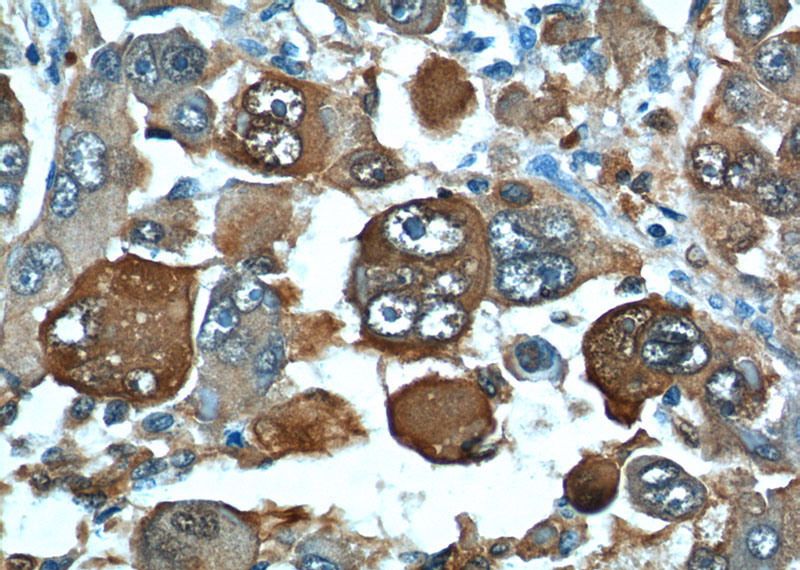
Immunohistochemistry of paraffin-embedded human liver cancer tissue slide using Catalog No:114963(S100A6 Antibody) at dilution of 1:200 (under 40x lens).

-
Product Name
S100A6 antibody
- Documents
-
Description
S100A6 Rabbit Polyclonal antibody. Positive WB detected in HeLa cells, A549 cells. Positive IP detected in A549 cells. Positive IHC detected in human liver cancer tissue, human colon cancer tissue, human lung cancer tissue. Positive IF detected in MCF-7 cells. Positive FC detected in MCF-7 cells. Observed molecular weight by Western-blot: 10 kDa
-
Tested applications
ELISA, WB, IF, FC, IP, IHC
-
Species reactivity
Human; other species not tested.
-
Alternative names
2A9 antibody; 5B10 antibody; CABP antibody; CACY antibody; Calcyclin antibody; MLN 4 antibody; PRA antibody; Protein S100 A6 antibody; S100A6 antibody
-
Isotype
Rabbit IgG
-
Preparation
This antibody was obtained by immunization of S100A6 recombinant protein (Accession Number: XM_017002033). Purification method: Antigen affinity purified.
-
Clonality
Polyclonal
-
Formulation
PBS with 0.1% sodium azide and 50% glycerol pH 7.3.
-
Storage instructions
Store at -20℃. DO NOT ALIQUOT
-
Applications
Recommended Dilution:
WB: 1:200-1:2000
IP: 1:500-1:5000
IHC: 1:50-1:500
IF: 1:20-1:200
-
Validations

HeLa cells were subjected to SDS PAGE followed by western blot with Catalog No:114963(S100A6 antibody) at dilution of 1:800
Immunohistochemistry of paraffin-embedded human liver cancer tissue slide using Catalog No:114963(S100A6 Antibody) at dilution of 1:200 (under 10x lens).
Immunohistochemistry of paraffin-embedded human liver cancer tissue slide using Catalog No:114963(S100A6 Antibody) at dilution of 1:200 (under 40x lens).

Immunofluorescent analysis of MCF-7 cells, using S100A6 antibody Catalog No:114963 at 1:50 dilution and Rhodamine-labeled goat anti-rabbit IgG (red). Blue pseudocolor = DAPI (fluorescent DNA dye).

1X10^6 MCF-7 cells were stained with 0.2ug S100A6 antibody (Catalog No:114963, red) and control antibody (blue). Fixed with 90% MeOH blocked with 3% BSA (30 min). Alexa Fluor 488-congugated AffiniPure Goat Anti-Rabbit IgG(H+L) with dilution 1:1000.

IP Result of anti-S100A6 (IP:Catalog No:114963, 3ug; Detection:Catalog No:114963 1:1000) with A549 cells lysate 2800ug.
-
Background
S100A6 is also named as calcyclin, prolactin receptor-associated protein (PRA), growth factor-inducible protein 2A9 ir MLN4. It belongs to S100 family of low molecular weight, acidic, calcium-binding proteins which contain two EF-hand calcium binding sites. S100A6 may function as a calcium sensor to activate several processes in the calcium signal transduction pathway of cell growth, proliferation, secretion and exocytosis. The antibody is specific for S100A6.
-
References
- Zhang J, Zhang K, Jiang X, Zhang J. S100A6 as a potential serum prognostic biomarker and therapeutic target in gastric cancer. Digestive diseases and sciences. 59(9):2136-44. 2014.
- Jiang GJ, Ma JY, Zhang GL. Protein profiling the differences between diabetic and normal mouse cumulus cells. Molecular reproduction and development. 81(12):1080-5. 2014.
- Xu NY, Zhang SP, Nie JH, Li JX, Tong J. Radon-induced proteomic profile of lung tissue in rats. Journal of toxicology and environmental health. Part A. 71(6):361-6. 2008.
- Xu NY, Zhang SP, Dong L, Nie JH, Tong J. Proteomic analysis of lung tissue of rats exposed to cigarette smoke and radon. Journal of toxicology and environmental health. Part A. 72(11-12):752-8. 2009.
- Shimamoto S, Kubota Y, Tokumitsu H, Kobayashi R. S100 proteins regulate the interaction of Hsp90 with Cyclophilin 40 and FKBP52 through their tetratricopeptide repeats. FEBS letters. 584(6):1119-25. 2010.
- Tani J, Shimamoto S, Mori K. Ca(2+) /S100 proteins regulate HCV virus NS5A-FKBP8/FKBP38 interaction and HCV virus RNA replication. Liver international : official journal of the International Association for the Study of the Liver. 33(7):1008-18. 2013.
Related Products / Services
Please note: All products are "FOR RESEARCH USE ONLY AND ARE NOT INTENDED FOR DIAGNOSTIC OR THERAPEUTIC USE"
